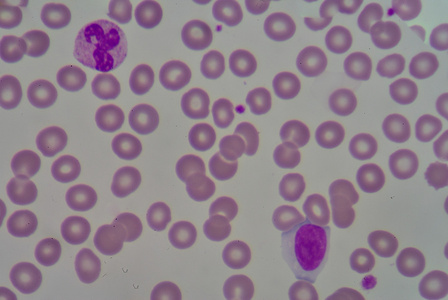
中性粒细胞与淋巴细胞照片
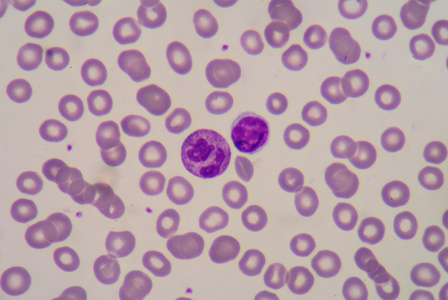
中性粒细胞和淋巴细胞照片

中性粒细胞淋巴细胞

预测乳腺癌,中性粒细胞/淋巴细胞之比(nlr)是重要数据
图片尺寸600x321
各种淋巴细胞及其它细胞
图片尺寸2000x2666
淋巴细胞篇(形态)787878
图片尺寸1080x1439
傻傻分不清的淋巴细胞
图片尺寸1000x750
淋巴细胞
图片尺寸1080x810
中间的淋巴细胞是成熟的吗
图片尺寸3264x2448
原始粒细胞 原始淋巴细胞 原始单核细胞
图片尺寸1080x810
淋巴细胞增高,真的那么简单吗?_学术交流_检验视界_检验视界网
图片尺寸559x398
带中性粒细胞淋巴照片
图片尺寸448x300
cd4 t淋巴细胞 hiv病毒靶细胞,免疫系统枢纽
图片尺寸1080x810
中性粒细胞和淋巴细胞
图片尺寸1200x900
中性粒细胞与淋巴细胞照片
图片尺寸448x300
淋巴细胞增多背后的原因大颗粒淋巴细胞
图片尺寸660x495
中性粒细胞和淋巴细胞照片
图片尺寸448x300
(2)细胞质无颗粒 分类 (2)lymphoid progenitor淋巴系祖细胞 (2
图片尺寸907x443
显微镜下的血液淋巴细胞
图片尺寸700x479
第八章 t淋巴细胞-1(杨琨,2010-12-7).ppt
图片尺寸1152x864
油镜下以成熟淋巴细胞为主,可见少量不典型淋巴细胞:低倍镜下骨髓增生
图片尺寸750x1000
带中性粒细胞淋巴细胞增多照片
图片尺寸448x300
9淋巴细胞 医学课件
图片尺寸1080x810